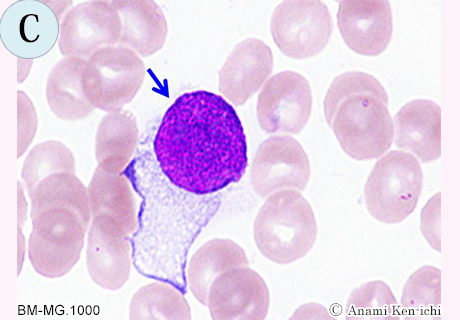

昭和の比類なきヒットメーカー、筒美京平さんが10月7日逝去されました。享年80歳でした。皆さんは、筒美さんをご存じない方もいらっしゃるかもしれませんが、毎週日曜に放映されているサザエさんのオープニングテーマ「サザエさん」は、誰もが口ずさめるのではないでしょうか。この楽曲は、1969年(昭和44年)筒美さんが作曲し、現在でもオープニングとして使用されています。筒美さんは、1940年(昭和15年)千葉県生まれの東京育ちで青山学院大学卒業後、作曲家すぎやまこういちに師事し、作曲家としてのキャリアをスタートしました。最初のヒット曲は、1968年(昭和43年)にリリースされた「ブルーライトヨコハマ」(歌:いしだあゆみ)で100万枚を超える大ヒットとなり、レコード大賞を受賞することになりました。その後、1970年代になると筒美さんが作曲した楽曲は、ヒットチャートの常連となり、1970年代では「魅せられて」(歌:ジュディオング)、「また逢う日まで」(歌:尾崎紀世彦)、「木綿のハンカチーフ」(歌:太田裕美)、1980年代は「スニーカーぶる∼す」(歌:近藤真彦)、「仮面舞踏会」(歌:少年隊)、1990年代には「人魚」(歌:NOKKO)、2000年代になると「AMBITIOUS JAPAN !」(歌:TOKIO)といったそれぞれの時代を代表する楽曲を世に送り出しました。
筒美さんは、自らを職業作曲家と称し、グループサウンズから歌謡曲、J-POPにアニソンなどジャンルに捉われない創作活動の中、1968年から1989年まで22年連続で作曲家年間売上TOP10にランクインし、生涯で手掛けた楽曲は約3,000曲、総売上げ枚数は7,560万枚(オリコン)に上ります。因みに総売上げ枚数の第2位は、あの小室哲哉(7,184万枚)ですので筒美さんの功績がどれほど凄かったかを理解できます。
一方、筒美さんの素顔はあまり知られていません。そのプライベートはほとんど謎で、インタビューやテレビ出演も数えるほどしかなく、私生活はベールに包まれたままでした。あくまで裏方として生きた筒美さんですが、作曲者の名は知らずとも筒美さんのメロディーは永遠に歌い続けることになるでしょう。現代は、マスメディアを利用し、積極的な露出や発言などから存在をアピールする時代となっていますが、プロの職人として裏方に徹した偉大な作曲家がいたことを忘れることなく、暫くは筒美さんのメロディーを口ずさみながら過ごしたいと思います。

天草タコ街道、道の駅有明“リップルランド” の白い歩道橋 から島原半島を眺め、筒美メロデイーを口ずさんだ憩いの一時
(撮影.阿南.202010.31.秋の日)
形態マガジン号キャプテン 阿南 建一

今回の細胞編は、骨髄像における鑑別細胞を出題しました。
骨髄で素通りされやすいのが非造血細胞です。造血細胞と同様に区分けのポイントをしっかり掴みましょう。
症例編は、僅かな検査所見を参考にして、骨髄の正常構築から逸脱した形態所見を理解して形態診断を行なって下さい。また、形態診断に不可欠な検査所見や鑑別疾患についても考えてみて下さい。
問題1
BM-MG.1000

BM-MG.1000

BM-MG.1000

BM-MG.1000

問題2
【60歳代】数年前に皮膚原発の悪性リンパ腫の診断。皮下結節あり。
WBC6.1万/μL、RBC201万/μL、Hb6.3g/dL、Ht20.2%、PLT6.2万/μL、CRP4.8mg/dL
PB-MG.400

PB-MG.600

PG-MG.1000

PG-MG.1000

問題 1
今回は、骨髄像における類似細胞と非造血細胞を提示しました。
【正答】
A-1.単球、2.前単球、3.分葉核球、4.好酸球
B-1.正染性赤芽球、2.好塩基性赤芽球、3.多染性赤芽球、4.桿状核球
C-細網細胞
D-1.多染性赤芽球、2.骨髄球、3.リンパ球、4.リンパ球
【解説】

A-1.細胞径15µm大、核は馬蹄形でクロマチン網工は繊細、細胞質はやや灰青色のことから単球と思われます。2.細胞径20µm大、大型で核形不整がみられ、クロマチン網工は繊細気味、細胞質は軽度の好塩基性に微細顆粒を有することから前単球と思われます。3.細胞径12µm大、核は分葉傾向でクロマチン網工は結節状、細胞質は薄い橙紅色で低顆粒の分葉核球と思われます。4.細胞径13µm大、核は二分葉で橙紅色の粗大顆粒を有する好酸球と思われます。

B-1.細胞径8µm大、細胞質は正染性の色調、円形核のクロマチン網工は粗荒で濃縮状のことから正染性赤芽球と思われます。2.細胞径14µm大、細胞質は好塩基性の色調、円形核のクロマチン網工は粗顆粒状のことから好塩基性赤芽球と思われます。3.細胞径12µm大、細胞質は多染性の色調、円形核のクロマチン網工は粗荒で凝集塊状のことから多染性赤芽球と思われます。2.と3.は類似していますが、細胞質の色調と核質は異なるものとして判定しました。4.細胞径12µm大、核は折れ曲がり、クロマチン網工はやや結節状、細胞質は薄い橙紅色で分散する顆粒は二次顆粒と見なし、桿状核球と思われます。
C.細胞径30µm大、核は円形で偏在し、クロマチン網工は繊細網状、細胞質は軽度の好塩基性で不整形、核は脱核の状態か、細胞質内に存在するかは不明ですが、形状から細網細胞と思われます。

D-1.細胞径11µm大、細胞質は多染性の色調で不規則性、円形核のクロマチン網工は凝集状というよりやや均一性です。核質に問題を残しますが、全体像から多染性赤芽球を疑いました。2.細胞径16µm大、核は円形でクロマチン網工は粗大粗荒で細胞質は一部好塩基性が残り、橙黄色が目立つことから骨髄球と思われます。3.細胞径14µm大、類円形核のクロマチン網工は粗荒で、細胞質は淡青色のことからリンパ球と思われます。4.細胞径13µm大、円形核のクロマチン網工は粗荒で細胞質は淡青色、顆粒は分散してみられることから顆粒リンパ球と思われます。2.と3.に核小体様がみられますが、クロマチンの集塊か染色過程のアーチファクトが考えられそうです。
問題 2
60歳代、三年前に多発性の紅色皮下出血を呈した皮膚性T細胞リンパ腫と診断されました。経過中に白血球数著増、貧血、血小板数減少を来した時の末梢血液像を提示しました。
【解説】




A.[PB-MG.400] 白血球数著増(7.1万/μL)の血液像で異型細胞を40%認めました。それらは、核形不整が顕著で核小体様を有し、単一様式から腫瘍性の異常リンパ球として捉えました。
B.[PB-MG.600] 異常リンパ球は、大型な歪な核形不整が特徴です。
C.[PB-MG.1000] 異常リンパ球は、大型でN/C比は低く、核は分葉し二核もみられ、クロマチン網工は粗荒で核小体様を有し、細胞質は中等度の好塩基性を呈しています。
D.[PB-MG.1000] 異常リンパ球の核異型性は、核分葉化が特徴的で核の隙間から細胞質が見えるほどの歪さがみられます。これらは、PO染色、PAS染色、EST染色に陰性でした。
【臨床診断】
末梢血に増加する異常リンパ球は、骨髄浸潤に伴う白血化が推測されました。異常リンパ球は、形態像からATLを疑いましたが、ATL細胞に比べ極端に大型で、核は濃染状ではなく、核分葉化は、核の隙間から細胞質が見えるほどの歪さを呈していたことから疑問が残りました。しかし、ATLとの鑑別は困難であり、ATLの証明に不可欠な抗HTLV-Ⅰ抗体は陰性でした。他に免疫形質は、CD4、CD30、HLA-DRが陽性でCD25は陰性でした。染色体・遺伝子は、49,XY+複雑核型、TCR遺伝子再構成を認めました。ATLを支持するCD25の陰性、抗HTLV-Ⅰ抗体の陰性からATLは除外し、CD30の陽性から皮膚CD30陽性T細胞リンパ腫(原発性皮膚未分化大細胞型リンパ腫)を考え、その再燃と診断されました。従来は、Ki-1抗体(抗CD30抗体)陽性のKi-1リンパ腫と呼ばれていた病型です。皮膚性T細胞リンパ腫には、本例やATLの他に、菌状息肉症、セザリー症候群などがありますので鑑別を要します。
© 2020 ベックマン・コールター株式会社
これから先のページでは、医療関係者の方々を対象に医療機器・体外診断薬等の製品に関する情報を提供しております。当社製品を適正に使用していただくことを目的としており、一部の情報では専門的な用語を使用しております。
一般の方への情報提供を目的としたものではありませんので、ご了承ください。
医療関係者の方は、次のページへお進みください。
(お手数ですが、「進む」ボタンのクリックをお願いします)